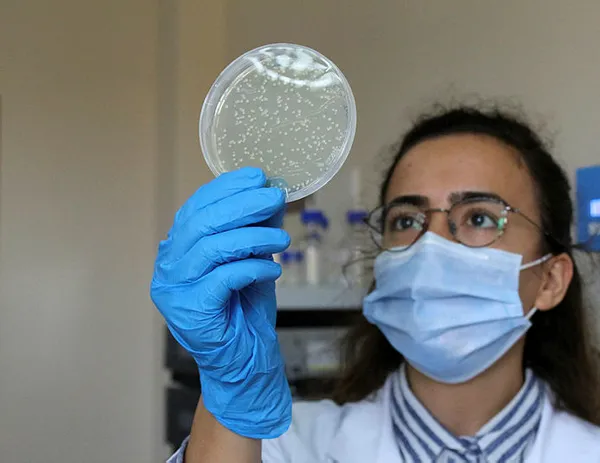

Türkiye'den koronavirüs çalışmalarında çığır açacak buluş! Tüm mutasyonlara karşı etkili!
Dünyayı kasıp kavuran yeni tip koronavirüsü durdurmak için bilim adamları gece gündüz demeden çalışırken Türkiye’den koronavirüs çalışmalarında çığır açacak bir buluş geldi. Türkiye Sağlık Enstitüleri Başkanlığı Biyoteknoloji Enstitüsü Aşı Bilim Kurulu Üyesi Prof. Dr. Tarlan Mammedov ve ekibinin Akdeniz Üniversitesi'ndeki (AÜ) koronavirüs aşısı çalışmalarında sona gelindi. Bitki yapraklarından protein üreterek koronavirüsün tüm mutasyonlarına karşı en etkili 5 aşı adayı geliştirdiklerini aktaran Prof. Dr. Mammedov, aşının hayvanlar üzerindeki denemesinin başarıyla sonuçlandığını, insanlar üzerinde denemelere başlayacaklarını duyurdu. Söz konusu aşının tüm mutasyonlara karşı etkili olduğu da beirtildi

Türkiye Sağlık Enstitüleri Başkanlığı Biyoteknoloji Enstitüsü Aşı Bilim Kurulu Üyesi ve AÜ Ziraat Fakültesi Enzim ve Mikrobiyal Biyoteknoloji Bölümü Öğretim Üyesi Prof. Dr. Tarlan Mammedov ile 20 kişilik ekibi, koronavirüs aşı çalışmasında sona geldi. 3 laboratuvar, 1 iklim odasında 'Transient Bitki Ekspresyon Sistemi' kullanarak, yeni nesil aşı çalışmalarını gerçekleştiren Prof. Dr. Mammedov, bir tür tütün bitkisi olan Nicotiana Benthamiana'nın, iklim odasında 22-24 derecede yüzde 50-60 nem seviyesinde özel formülasyon içeren gübrelerle yetiştirilerek belli büyüklüğe ulaşmasını sağladıklarını anlattı. Bitkiye, yeniden düzenleme yapılıp bitki yaprağının içine solüsyon verilerek yapraklarından protein ürettiklerini belirten Prof. Dr. Tarlan Mammedov, gerekli analizler sonucunda 5 aşı çeşidi ürettiklerini aktardı. Prof. Dr. Mammedov, protein içerikli üretilen aşıların koronavirüsün tüm mutasyonlarına karşı etkili olduğunu vurgulayarak, hayvanlar üzerindeki deneylerde başarılı olduklarını, artık insanlar üzerinde aşı denemelerinin başlayacağını açıkladı.

3 AŞI ADAYI HAYVANLAR ÜZERİNDE BAŞARILI OLDU
Prof. Dr. Tarlan Mammedov, nisan ayında başlayan aşı çalışmalarında başarı elde ettiklerini belirterek, 5 aşı adayı geliştirdiklerini anlattı. Aşı adaylarının 3'ünün hayvan testlerinden geçtiğini aktaran Prof. Dr. Mammedov, "Hayvanlar üzerindeki test sonuçlarına göre koronavirüse karşı aşı adaylarının hayvanlarda yüksek miktarda fonksiyonel antikor ürettiğini kanıtladık. Bundan sonra insanlar üzerinde testlere geçebiliriz" dedi.

KORONAVİRÜSÜN TÜM MUTASYONLARINA KARŞI ETKİLİ
Protein temelli aşılar geliştirdiklerini aktaran Prof. Dr. Mammedov, "Bitki yapraklarından protein ürettik. İstenilen bir geni bitki yapraklarının hücrelerine aktararak, bu genlerin ürünleri olan enzimleri ürettik. Geliştirdiğimiz aşıların başka aşılardan özellikleri, üstünlükleri ve avantajları var. Bu aşılarda virüs ve bakteri yok. Protein temelli aşılar güvenlidir. 1500'ten çok koronavirüs proteininin analizlerini yaptık ve ona göre çalışmalarımızı sürdürdük. Koronavirüsün birçok mutasyonuna karşı çok etkili olacağını düşünüyoruz" diye konuştu.

ANTİKOR SEVİYESİNİ ÖLÇEN 3 AYRI KİT GELİŞTİRİLDİ
Koronavirüs hastalarının antikor seviyelerinin belirlenmesinin çok önemli olduğunu vurgulayan Prof. Dr. Tarlan Mammedov, "Eğer antikor seviyeleri yüksek olursa bu kişilerin koronavirüse yakalanma riskinin az olduğu anlamına gelir. Antikor seviyesi az olursa bu insanların yeniden koronavirüs hastalığına tutulma ihtimali, riski çok yüksektir. Onun için Covid-19'a karşı antikor seviyesinin tayin edilmesi çok önemli. Bu konuyla ilgili 3 kit geliştirdik. Bu kitler Covid-19'a karşı antikor seviyelerini belirlemek için kullanılabilir" dedi.

KORONAVİRÜS HASTALARINDA AZALAN ACE2 ENZİMİNİ BİTKİLERDEN ÜRETTİLER
İnsan vücudunda önemli bir yere sahip olan anjiyontensin dönüştürücü enzim 2 (ACE2) üzerine çalıştıklarını aktaran Prof. Dr. Tarlan Mammedov, "Covid-19'un özelliklerinden biri MERS virüsünün reseptörüdür. ACE2 enzimi virüs tarafından bloke olur. ACE2 enziminin bedende az miktarda olması insanlarda büyük problemlere neden olabilir. Özellikle yoğun bakımda olan hastalar, bu enzim miktarının az olması nedeniyle hastalığı ağır geçiriyor olabilir. Bu enzimi Transient Bitki Ekspresyon Sistemi'nde yüksek miktarda oluşturulmasını sağladık" diye konuştu.
Enzimin genetik mühendislik yoluyla bitkiden üretildiğini aktaran Prof. Dr. Mammedov, yüksek miktarda üretilmesinde başarılı olduklarını açıkladı. Prof. Dr. Mammedov, "500 grama kadar çıkan ACE2 enzimini, 1 kilogram bitki yaprağından üretebildik. Covid-19 nedeniyle özellikle yoğun bakımda kalan hastalara uygulanabilir. Böyle bir enzimin insan vücuduna mühim miktarda dahil edilebilmesi bu insanların hayatını kurtarabilir" dedi.